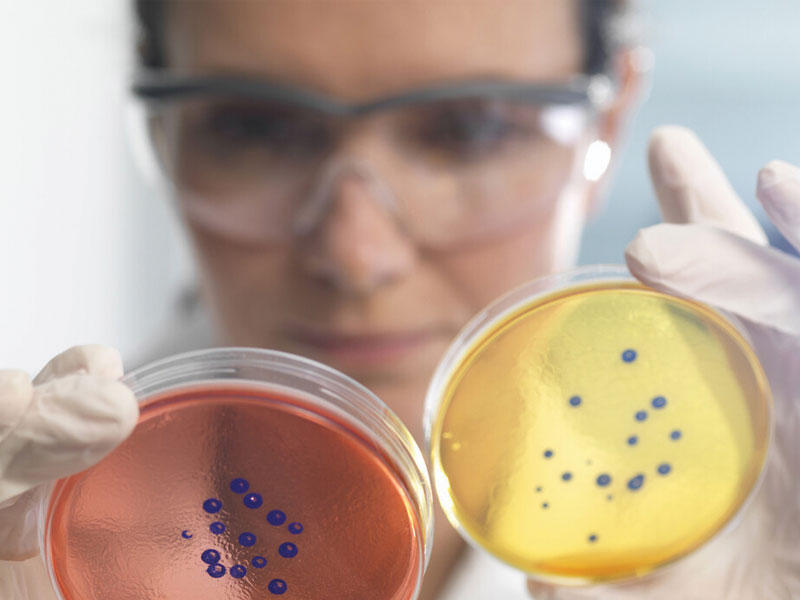

البكتيريا لا تموت!
اكتشف العلماء نشاطاً غير متوقّع في البكتيريا الخاملة، وأظهروا لأول مرة أنه حتى عندما تكون «ميتة» من الناحية الفسيولوجية، فإنّها تظل على دراية بمحيطها.وباستخدام مخزون من الجسيمات المشحونة بالطاقة، بدلاً من الوقود المعتاد، يمكن للبكتيريا أن تستجيب بنشاط للتغيرات الصغيرة في مستوى المغذيات لتحديد وقت الذروة للاستيقاظ.
ويتحدّى هذا الاكتشاف فهم العلماء، ليس فقط لكيفية انتشار المرض، ولكن أيضاً كيف يمكن للحياة أن تنجو في الحالات المتطرفة هنا على الأرض وما بعدها.
ويقول عالم الأحياء الجزيئية الباحث الرئيسي، جورول سول، (من جامعة كاليفورنيا في سان دييغو) في الورقة البحثية التي نقلها موقع روسيا اليوم، أمس الأول: «يغيّر هذا العمل طريقة تفكيرنا في الأبواغ pollen التي كانت تعدّ كائنات خاملة. لقد أظهرنا أن الخلايا وهي في حالة سبات عميق لديها القدرة على معالجة المعلومات، واكتشفنا أن الأبواغ يمكنها إطلاق الطاقة الكهروكيميائية الكامنة المخزّنة لديها لإجراء حساب حول بيئتها من دون الحاجة إلى نشاط التمثيل الغذائي».والأبواغ هي خلايا تحيط بالبكتيريا وتمكّنها من البقاء على قيد الحياة عند اشتداد قساوة الظروف المحيطة.والأبواغ البكتيرية توضّح كيف يمكن لأمراض مثل الجمرة الخبيثة، التي تسببها البكتيريا الخبيثة Bacillus anthracis، أن تعيش فترات طويلة دون ماء أو مغذيات في البريد، أن تصبح في غضون لحظات من التعرّض لظروف مناسبة من الترطّب والتمثيل الغذائي مجدداً، مما يسمح لها بأن تصبح مُعدية مرة أخرى.